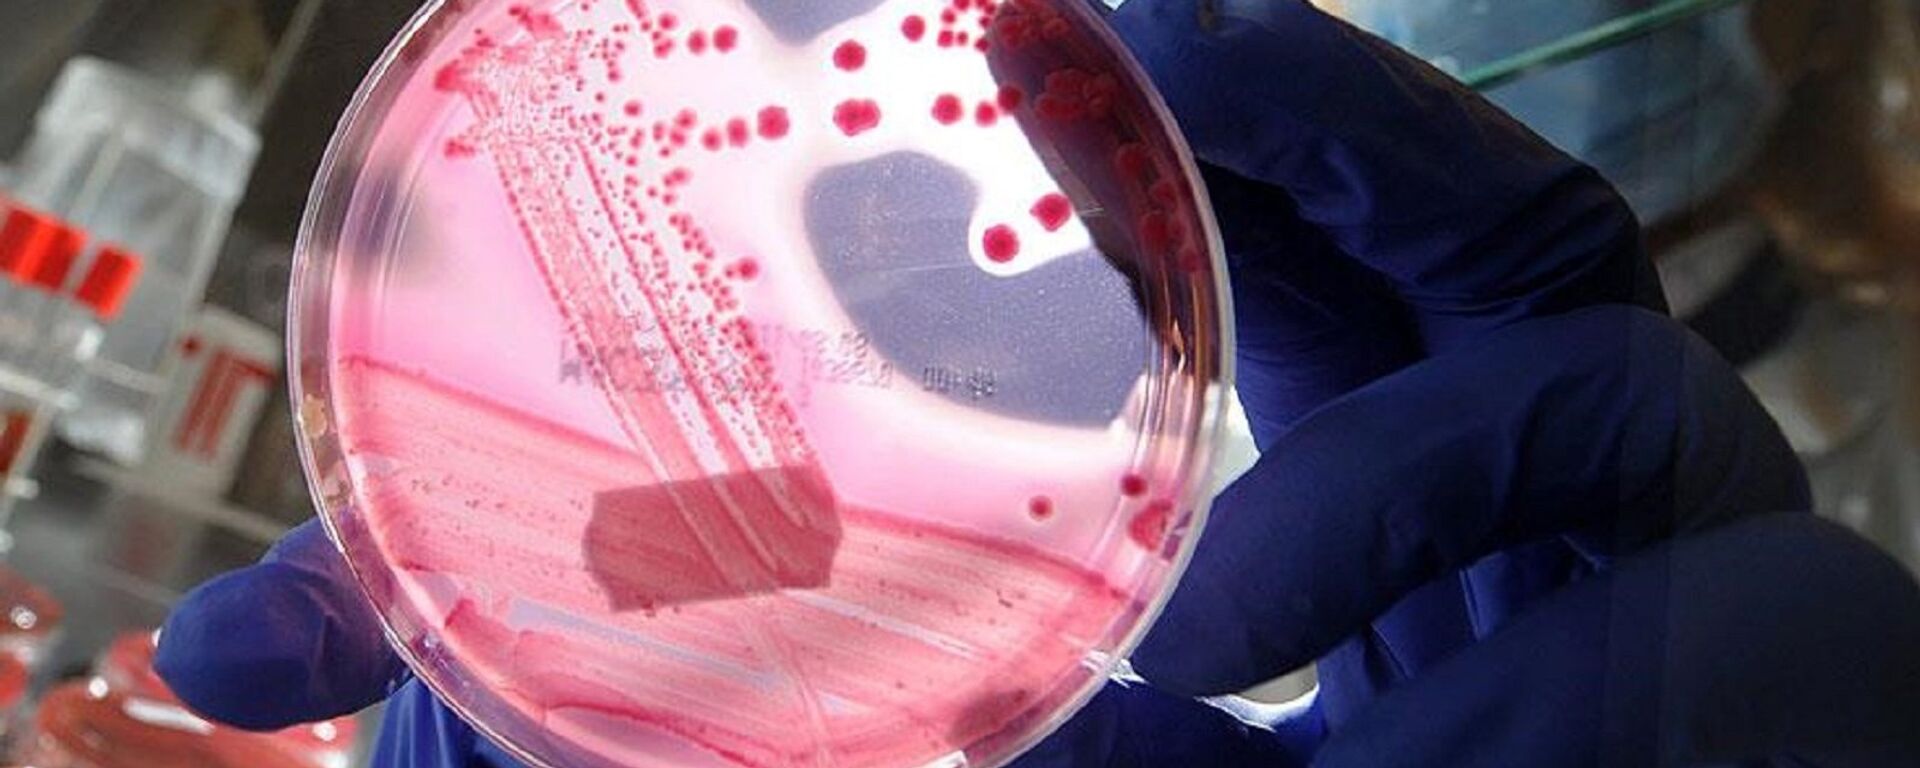
DNA, genetik, deney, gen mühendisliği - Sputnik Türkiye, 1920, 13.04.2026

https://anlatilaninotesi.com.tr/20260414/metabolik-karaciger-hastaligi-alarm-veriyor-2050ye-kadar-18-milyar-kisi-risk-altinda-1104996437.html
Metabolik karaciğer hastalığı alarm veriyor: 2050'ye kadar 1,8 milyar kişi risk altında
Metabolik karaciğer hastalığı alarm veriyor: 2050'ye kadar 1,8 milyar kişi risk altında
Sputnik Türkiye
Yeni bir araştırmaya göre metabolik karaciğer hastalığı dünya genelinde hızla artmaya başladı. Uzmanlar, obezite ve yüksek kan şekerinin etkisiyle 2050'ye... 14.04.2026, Sputnik Türkiye
2026-04-14T11:28+0300
2026-04-14T11:28+0300
2026-04-14T11:33+0300
sağlik
washington üniversitesi
ihme
karaciğer
risk
hastalık belirtileri
https://cdn.img.anlatilaninotesi.com.tr/img/07e6/04/1d/1055959560_0:0:1600:900_1920x0_80_0_0_f33b7d45252d03cbfe49b958606bd192.jpg
Bilimsel araştırmalar, metabolik karaciğer hastalığının küresel ölçekte hızla yayıldığını ortaya koydu. Karaciğer yağlanması olarak da bilinen ve son zamanlarda Metabolik Disfonksiyonla İlişkili Steatotik Karaciğer Hastalığı (MASLD) olarak adlandırılan hastalığın, 2050 yılına kadar yaklaşık 1,8 milyar kişiyi etkilemesi bekleniyor.Önceden literatürde 'alkol dışı yağlı karaciğer hastalığı' olarak isimlendirilen bu hastalık, günümüzde en yaygın ve en hızlı artan karaciğer rahatsızlıkları arasında yer almakta.Vaka sayısı 30 yılda katlandıWashington Üniversitesi'ne bağlı küresel sağlık sorunları üzerinde bağımsız araştırma yapan Sağlık Ölçütleri ve Değerlendirme Enstitüsü (IHME) tarafından yürütülen ve The Lancet Gastroenteroloji & Hepatoloji dergisinde yayımlanan araştırmaya göre:Bu da son 30 yılda yüzde 143’lük bir artış anlamına geliyor. Günümüzde her 6 kişiden biri (yaklaşık yüzde 16) bu hastalıktan etkileniyor.Artışın temel nedenleri neler?Araştırmaya göre hastalığın yayılmasının başlıca nedenleri:Özellikle yüksek kan şekeri, MASLD’ye bağlı sağlık sorunlarının en önemli tetikleyicisi olarak öne çıkıyor. Bu durum, hastalığın Tip-2 Diyabet ve obezite ile güçlü bağlantısını ortaya koyuyor.Hangi yaş grupları daha riskli?Araştırma, hastalığın en sık ileri yaş grubunda (80-84 yaş) görüldüğünü ortaya koyarken, toplam vaka sayısının daha genç yaş gruplarında yoğunlaştığını gösteriyor:Belirti göstermeden ilerleyebiliyorKaraciğer yağlanması çoğu zaman belirti göstermeden ilerliyor. Bu nedenle birçok kişi hastalığa sahip olduğunu fark etmiyor.Olası belirtiler arasında:yer aldı.
https://anlatilaninotesi.com.tr/20260413/insan-omrunde-genetik-etkisi-sanilandan-en-az-2-kat-daha-fazla-1104982553.html
Sputnik Türkiye
feedback.tr@sputniknews.com
+74956456601
MIA „Rossiya Segodnya“
2026
Sputnik Türkiye
feedback.tr@sputniknews.com
+74956456601
MIA „Rossiya Segodnya“
SON HABERLER
tr_TR
Sputnik Türkiye
feedback.tr@sputniknews.com
+74956456601
MIA „Rossiya Segodnya“
Sputnik Türkiye
feedback.tr@sputniknews.com
+74956456601
MIA „Rossiya Segodnya“
washington üniversitesi, ihme, karaciğer, risk, hastalık belirtileri
washington üniversitesi, ihme, karaciğer, risk, hastalık belirtileri
Metabolik karaciğer hastalığı alarm veriyor: 2050'ye kadar 1,8 milyar kişi risk altında
11:28 14.04.2026 (güncellendi: 11:33 14.04.2026) Yeni bir araştırmaya göre metabolik karaciğer hastalığı dünya genelinde hızla artmaya başladı. Uzmanlar, obezite ve yüksek kan şekerinin etkisiyle 2050'ye kadar 1,8 milyar kişinin bu hastalıktan etkilenebileceğini belirtti. Araştırmaya göre vaka sayısı son 30 yılda yüzde 143 oranında arttı.
Bilimsel araştırmalar, metabolik karaciğer hastalığının küresel ölçekte hızla yayıldığını ortaya koydu. Karaciğer yağlanması olarak da bilinen ve son zamanlarda Metabolik Disfonksiyonla İlişkili Steatotik Karaciğer Hastalığı (MASLD) olarak adlandırılan hastalığın, 2050 yılına kadar yaklaşık 1,8 milyar kişiyi etkilemesi bekleniyor.
Önceden literatürde 'alkol dışı yağlı karaciğer hastalığı' olarak isimlendirilen bu hastalık, günümüzde en yaygın ve en hızlı artan karaciğer rahatsızlıkları arasında yer almakta.
Vaka sayısı 30 yılda katlandı
Washington Üniversitesi'ne bağlı küresel sağlık sorunları üzerinde bağımsız araştırma yapan Sağlık Ölçütleri ve Değerlendirme Enstitüsü (IHME) tarafından yürütülen ve The Lancet Gastroenteroloji & Hepatoloji dergisinde yayımlanan araştırmaya göre:
1990’da yaklaşık 500 milyon kişi hastalıkla yaşıyordu
2023’te bu sayı 1,3 milyara yükseldi
2050’de ise 1,8 milyara ulaşması bekleniyor Bu da son 30 yılda yüzde 143’lük bir artış anlamına geliyor. Günümüzde her 6 kişiden biri (yaklaşık yüzde 16) bu hastalıktan etkileniyor.
Artışın temel nedenleri neler?
Araştırmaya göre hastalığın yayılmasının başlıca nedenleri:
Yükselen obezite oranları Sağlıksız yaşam tarzı alışkanlıkları Özellikle yüksek kan şekeri, MASLD’ye bağlı sağlık sorunlarının en önemli tetikleyicisi olarak öne çıkıyor. Bu durum, hastalığın Tip-2 Diyabet ve obezite ile güçlü bağlantısını ortaya koyuyor.
Hangi yaş grupları daha riskli?
Araştırma, hastalığın en sık ileri yaş grubunda (80-84 yaş) görüldüğünü ortaya koyarken, toplam vaka sayısının daha genç yaş gruplarında yoğunlaştığını gösteriyor:
Erkeklerde en fazla 35-39 yaş Kadınlarda en fazla 55-59 yaş Belirti göstermeden ilerleyebiliyor
Karaciğer yağlanması çoğu zaman belirti göstermeden ilerliyor. Bu nedenle birçok kişi hastalığa sahip olduğunu fark etmiyor.
Olası belirtiler arasında:
Kaburgaların sağ altında ağrı veya rahatsızlık